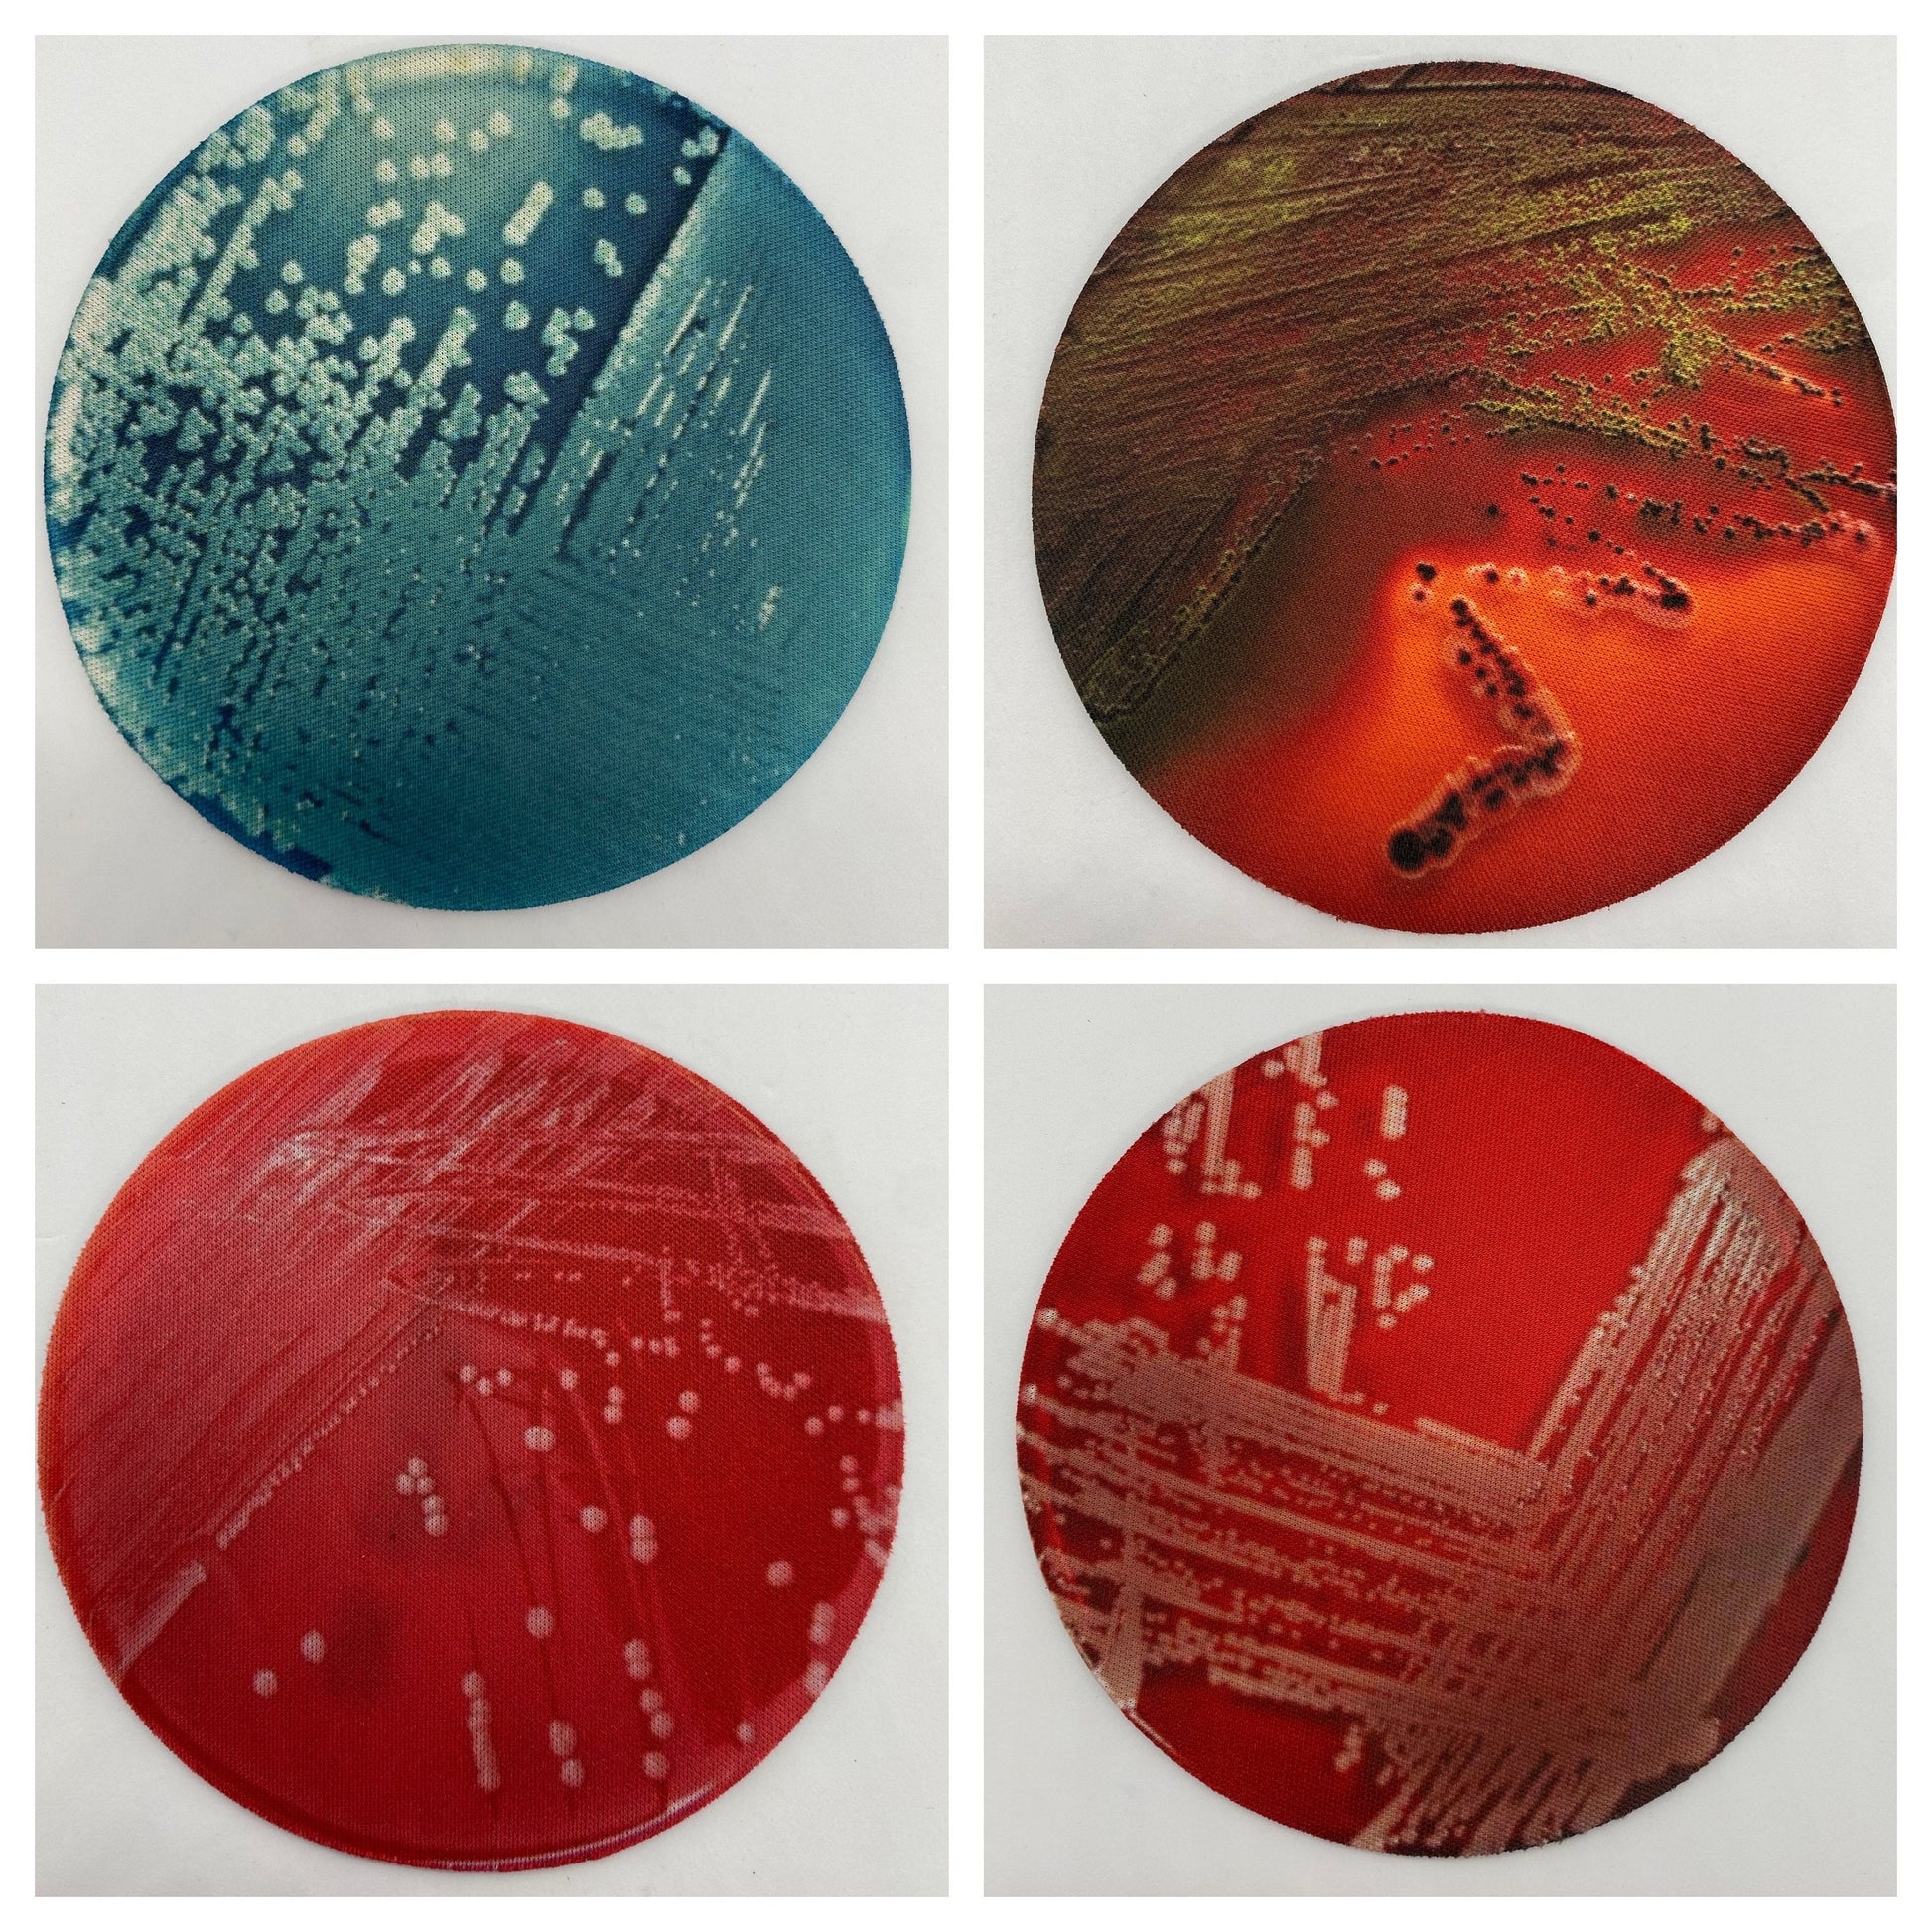
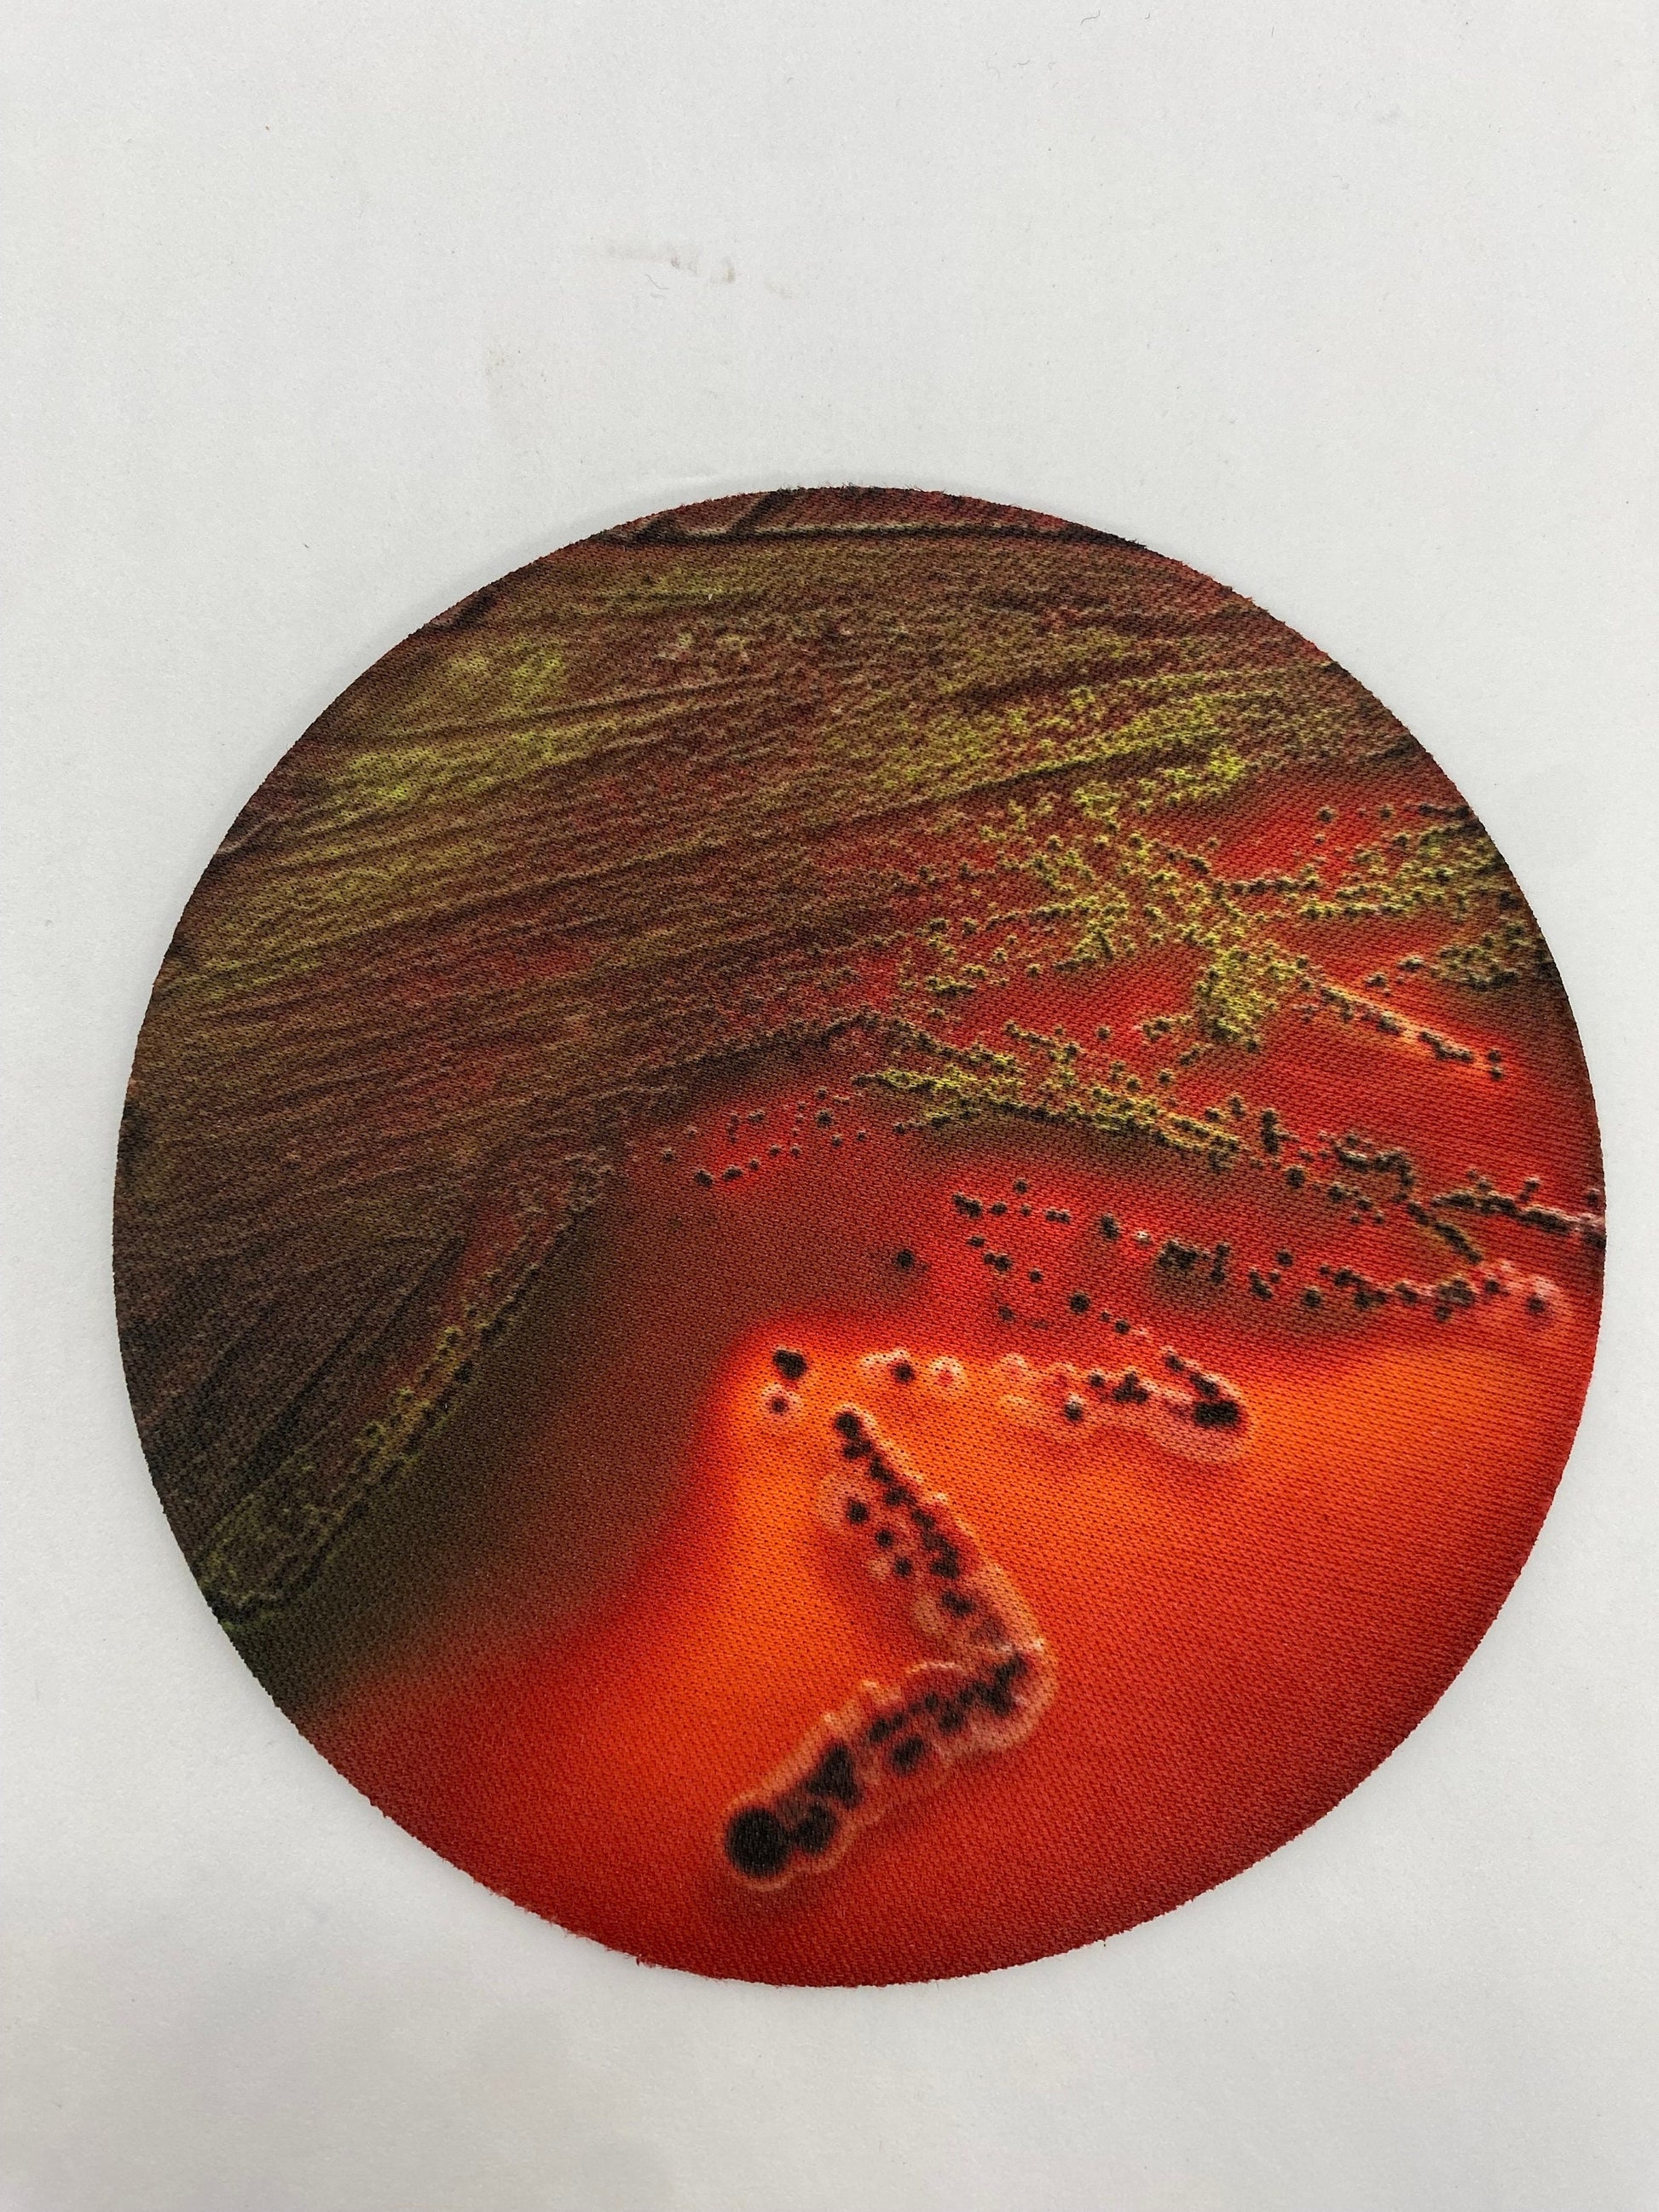
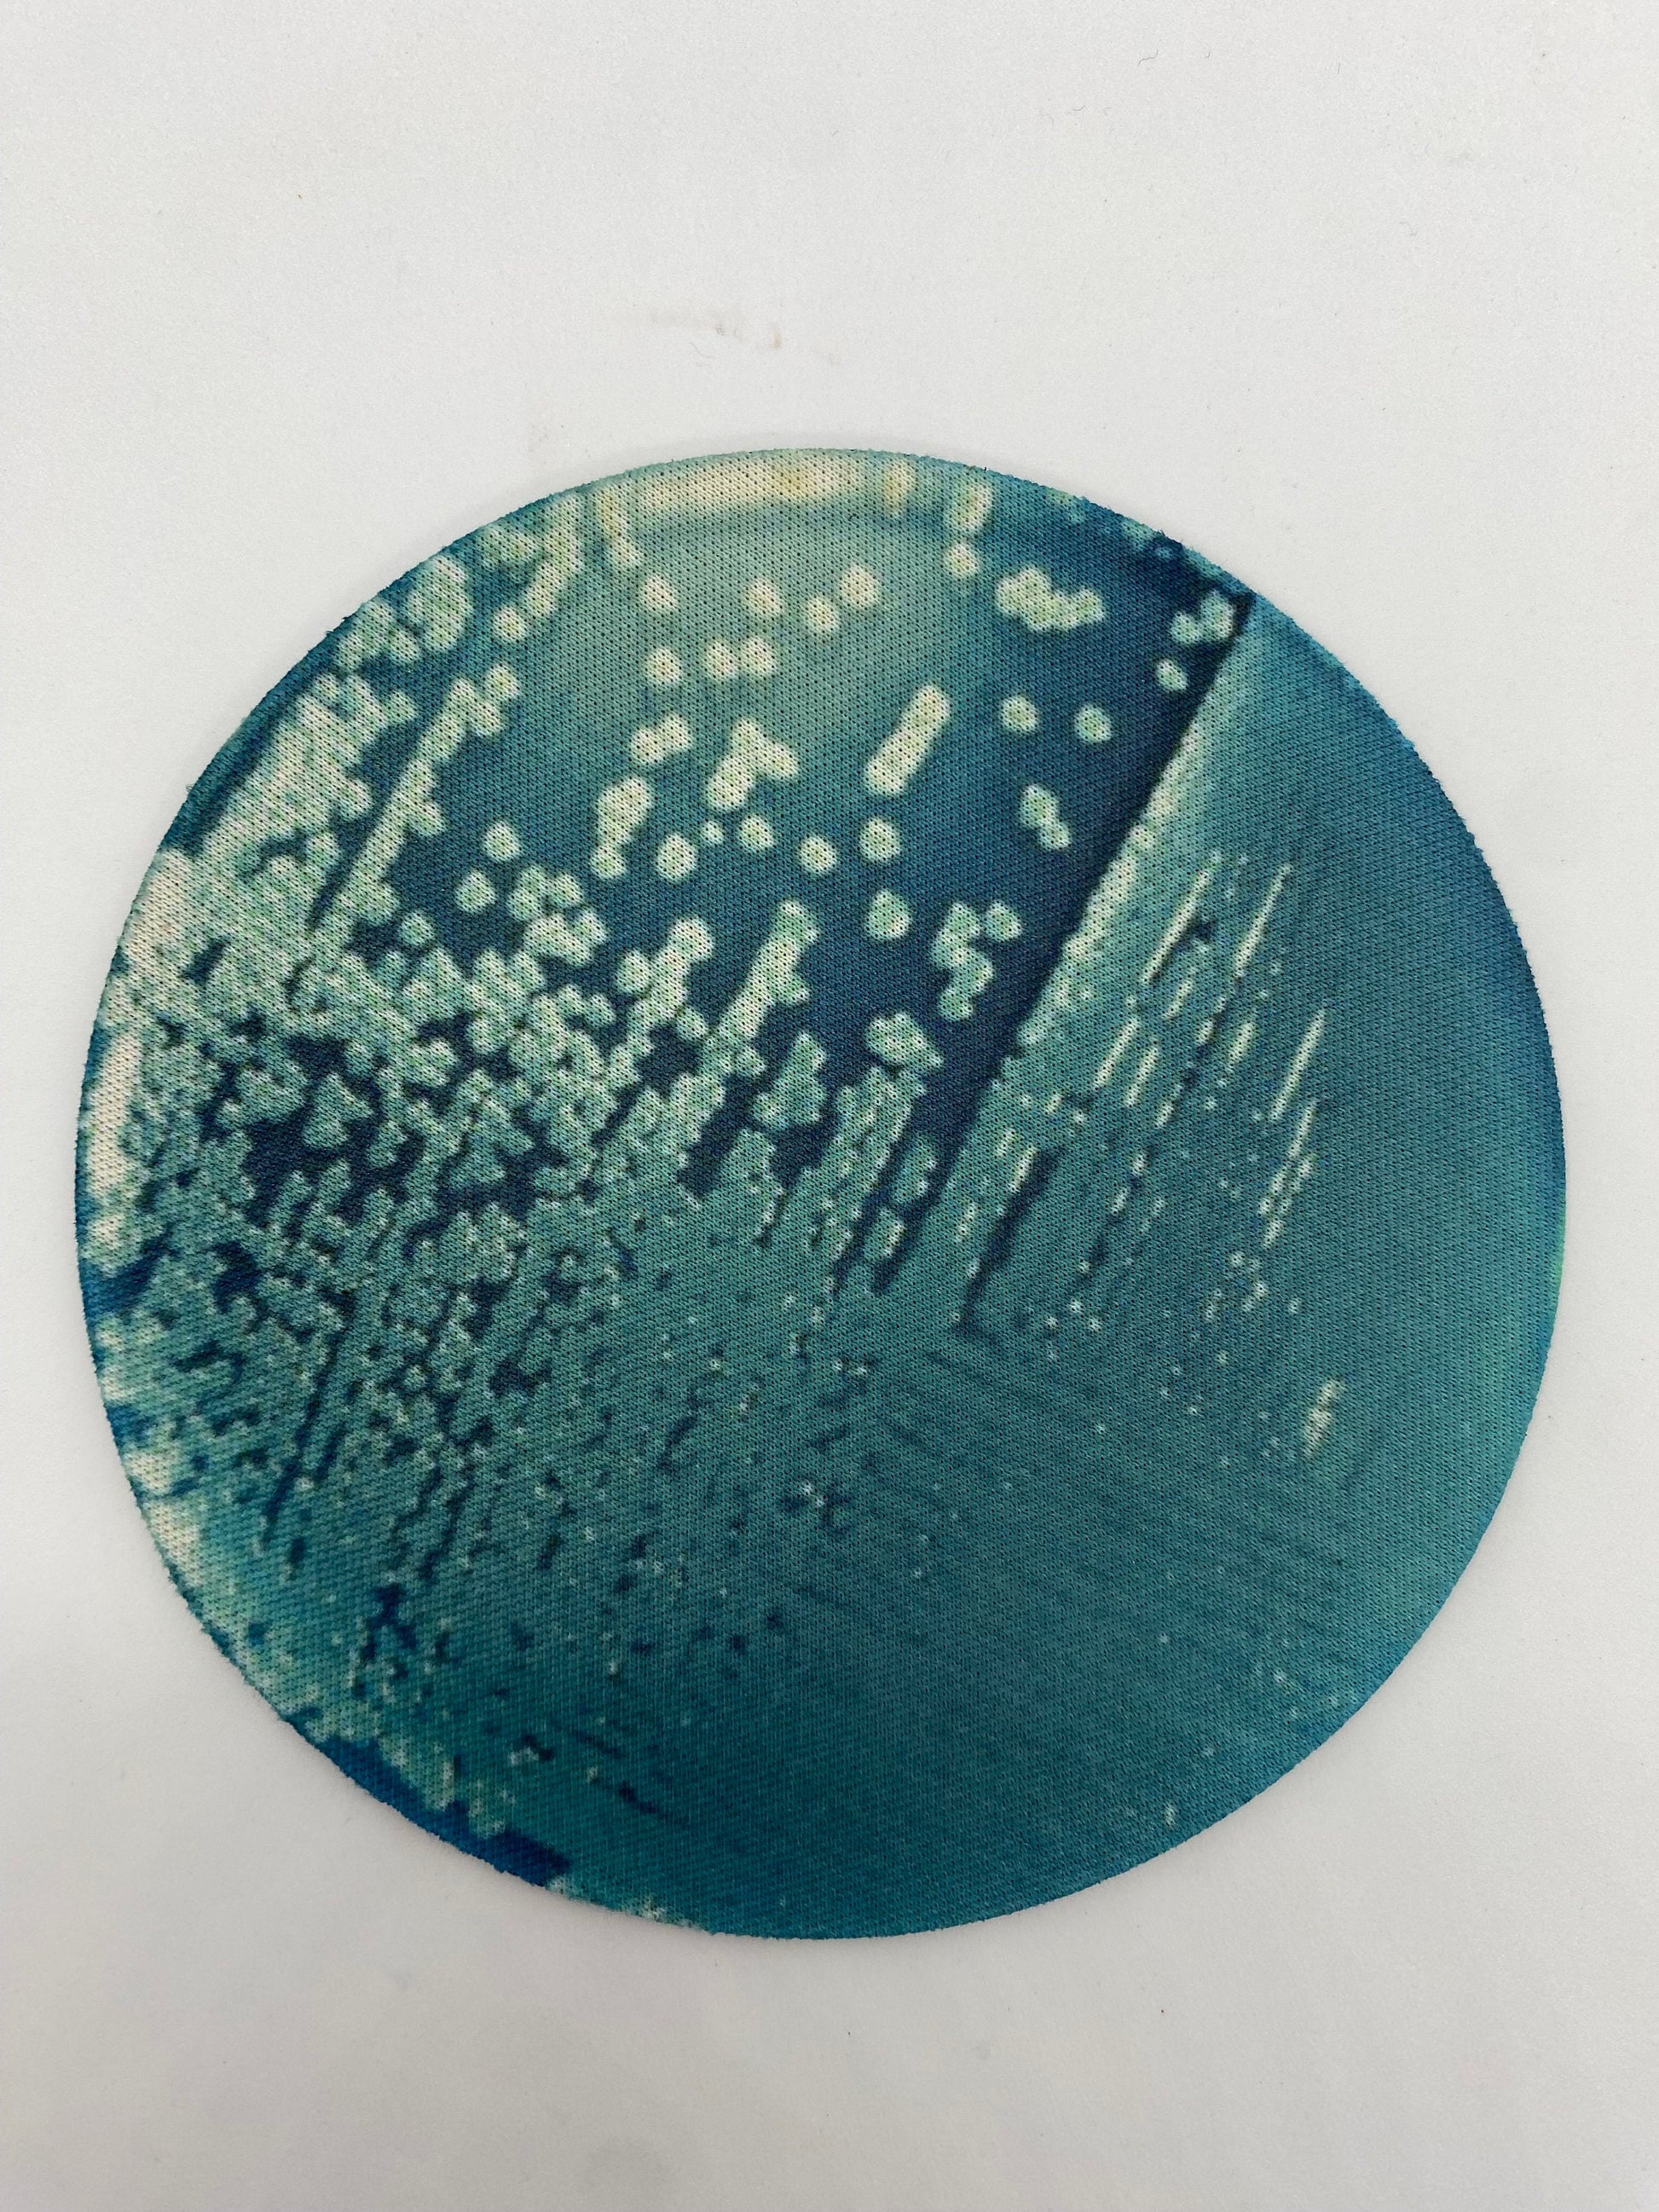
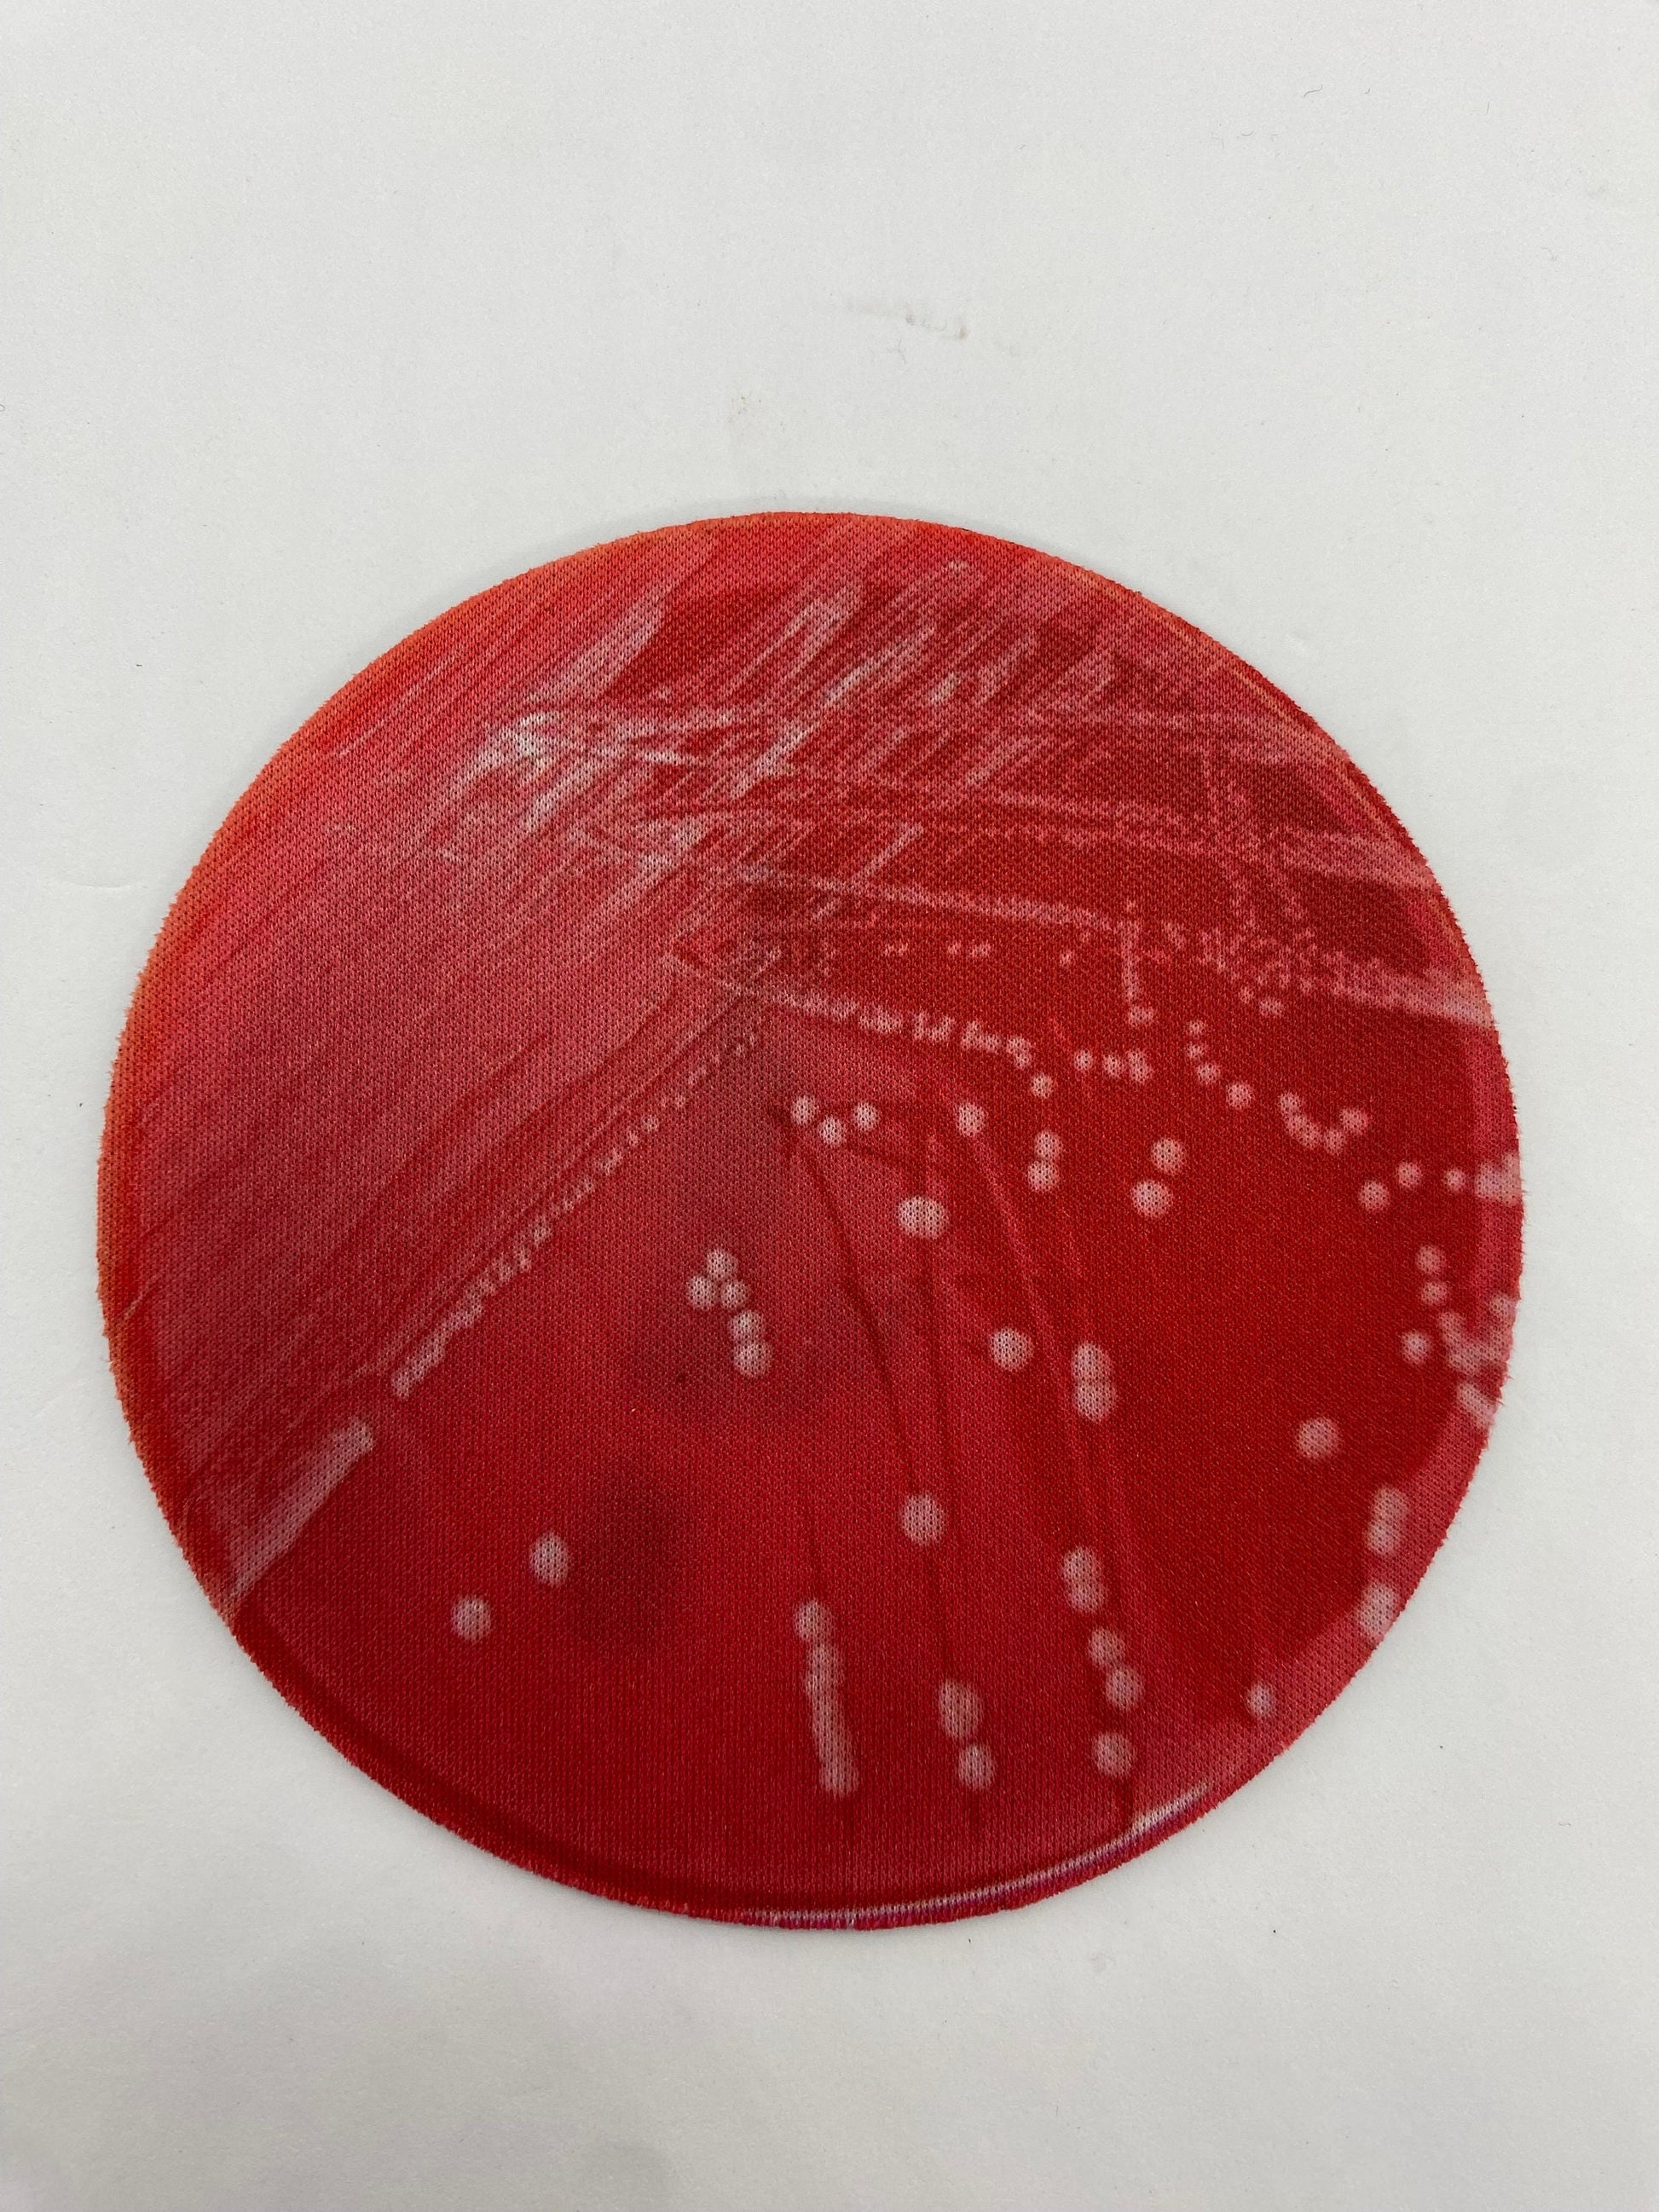
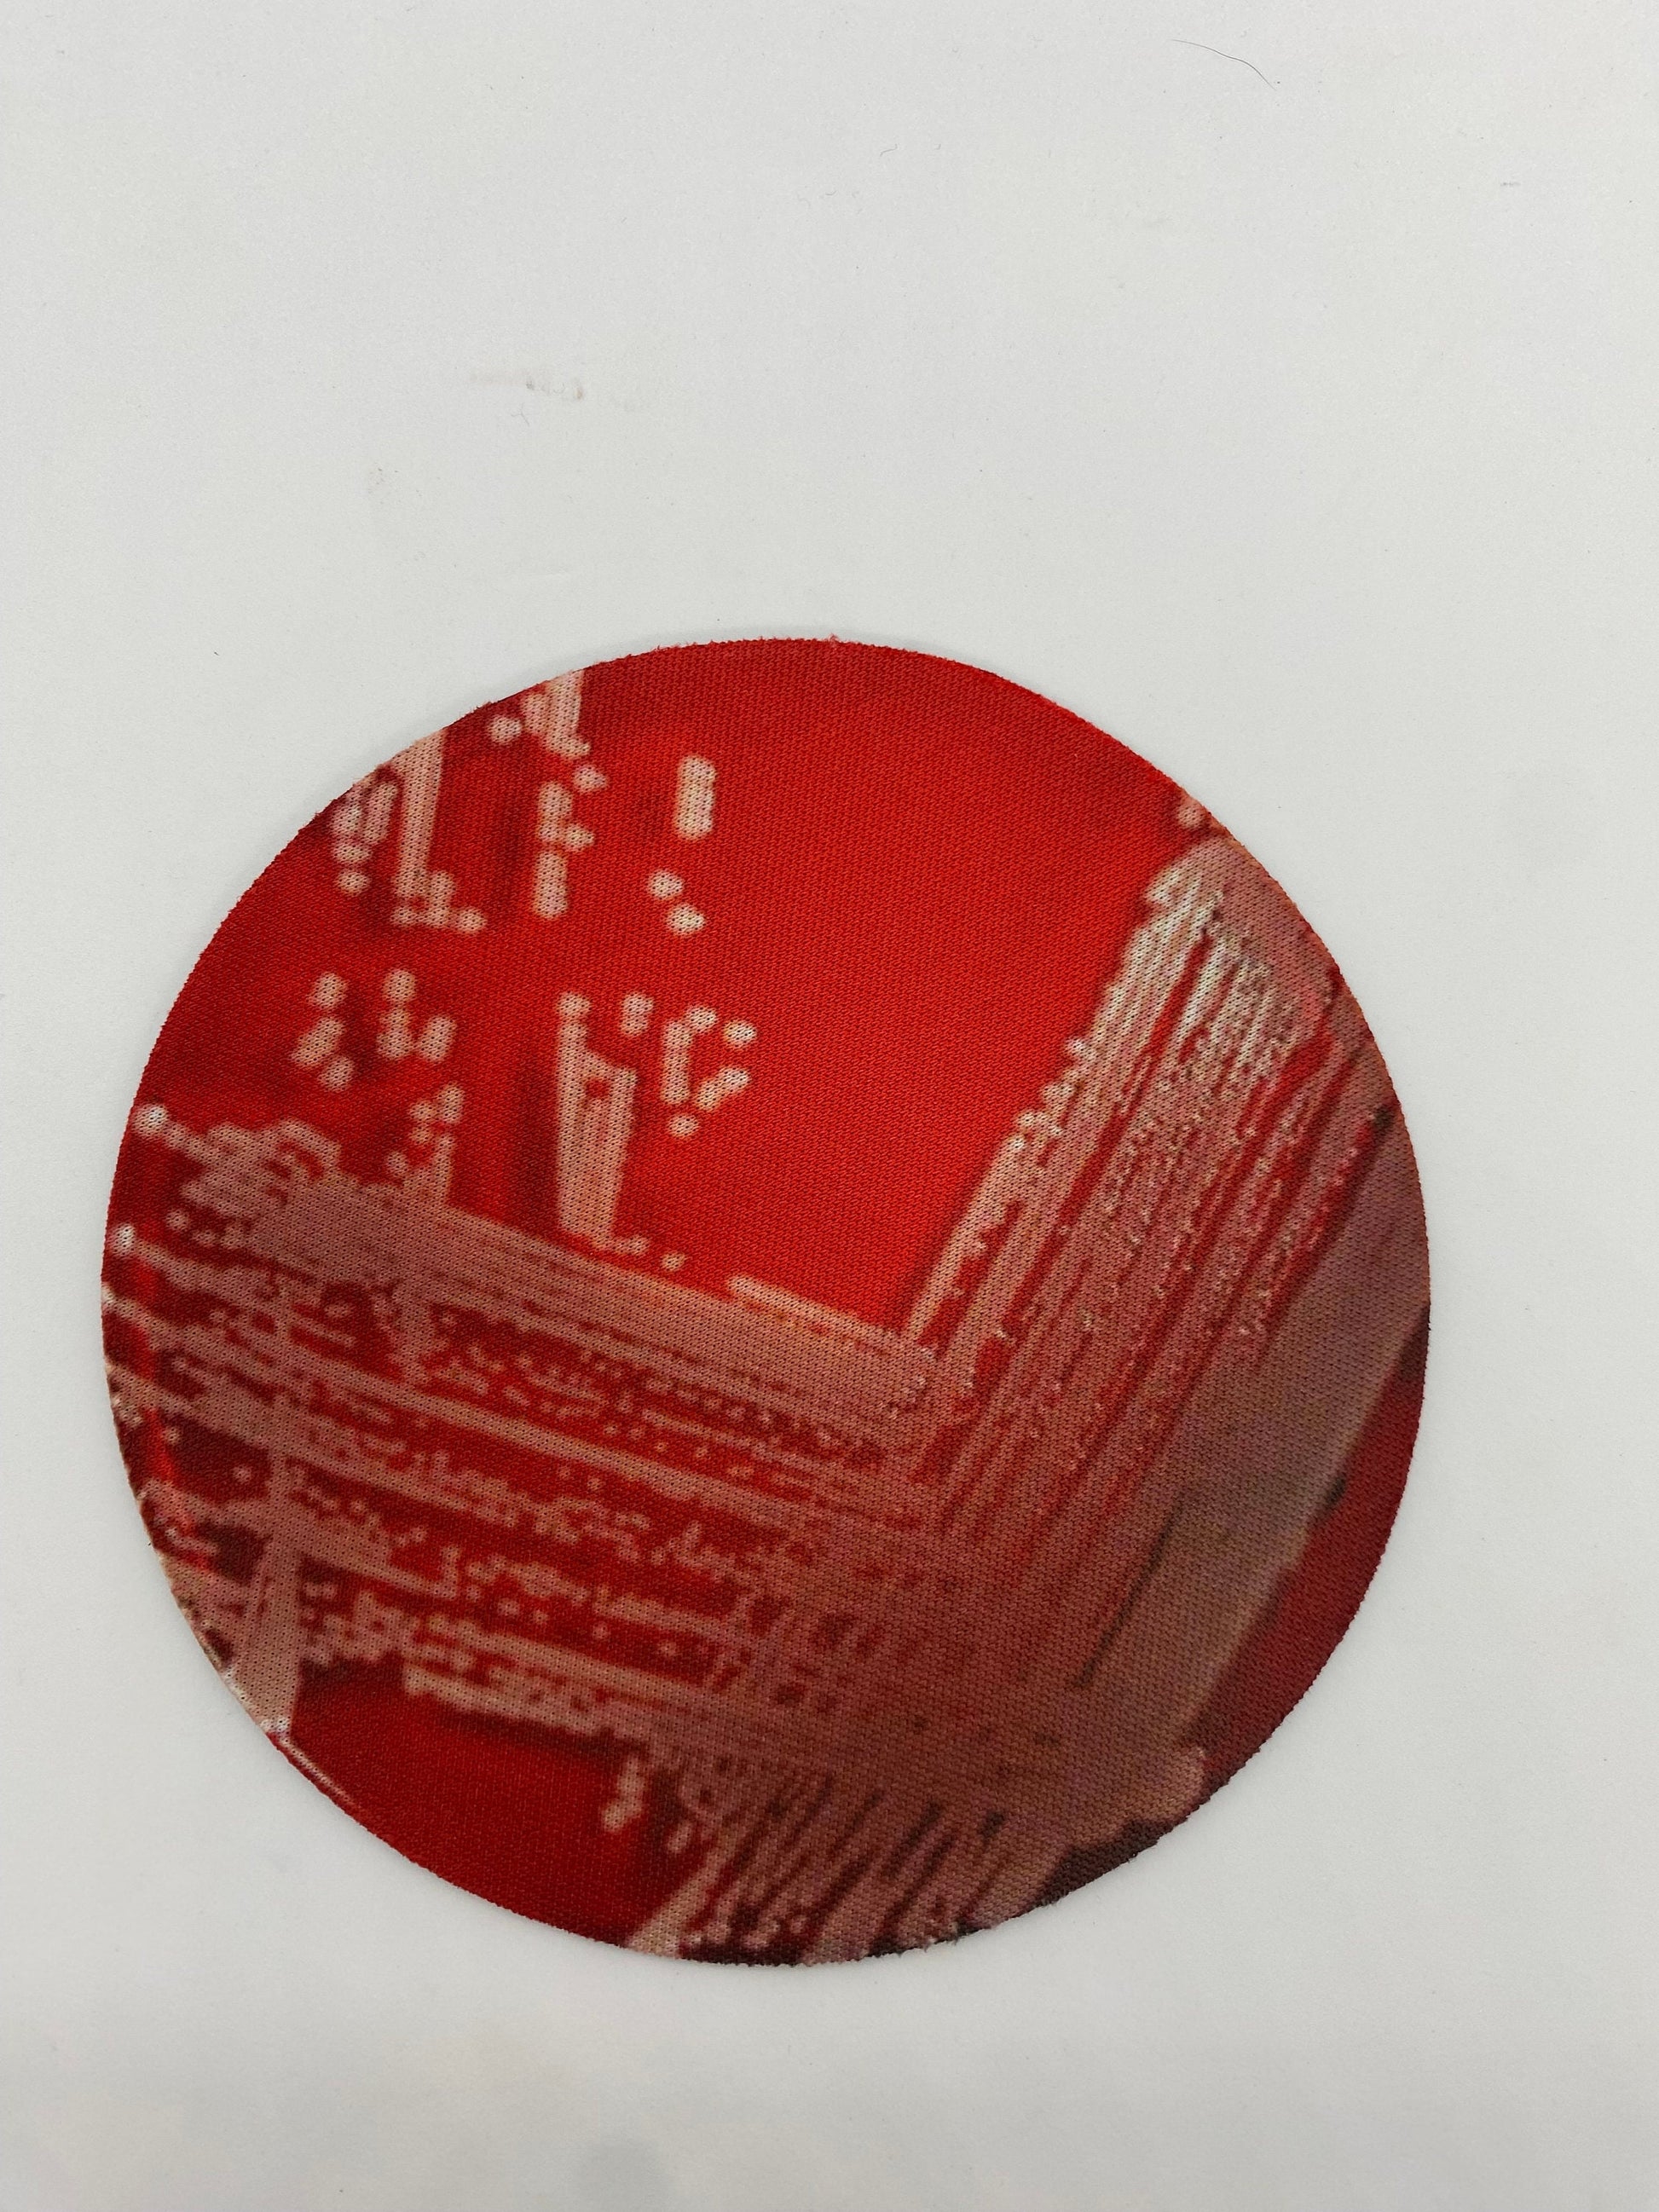

NinjaWombats
Bacterial Pathogen Neoprene Coasters - Bacteria, Petri Dish | Fun Gift for Microbiologists, Infectious Disease, Teachers, Lab Techs
Couldn't load pickup availability
These neoprene/plastic coasters represent some of my favorite bacterial pathogens. I have printed plates of Escherichia coli (abbreviated as E. coli, found in the GI tract), Pasteurella multocida (commonly found in cat bite wounds), Pseudomonas aeruginosa (the bad boy of nosocomial infections), and Staphylococcus aureus (which can also be a bad boy of nosocomial infections, especially when it's MRSA).
If I missed your favorite pathogen, message me and I might be able to make it into a coaster too.
These are thin, neoprene coasters (please look at all the photos, they fold), but they're actually quite efficient at being a coaster. They have a polyester layer on top and absorb liquid pretty well.
You get all four! Gross-out your friends (or impress them if they're cool).
*Etsy won't let me italicize the scientific names, sorry science.
Details and Care
Details and Care
Graphics were drawn by me, but notebooks will be printed and fulfilled through our production partner.
Product features - 5.75"x8'
- Matte laminated cover for durability
- Vibrant colors with crisp printing
- Perforated pages for easy tearing
- Casewrap binding for flexibility
- Full wraparound print Care instructions
- Use a soft, clean and dry cloth to gently brush any dust or dirt off from the center of book outwards.